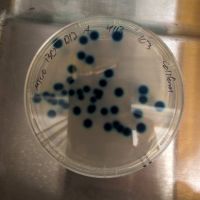
Some E. coli bacteria on a dish - courtesy of Tessa Andermann

A personal approach to the biology of stress
An NC TraCS pilot award unites researchers from medical and engineering backgrounds to develop a wearable device for tracking stress.
Stress, that nebulous mixture of anxiety and tension, comes in many different forms.
Aysenil Belger, PhD
Often, stress can be temporary—and even beneficial for productivity—such as the nerves you might feel before a big meeting or before running a marathon, helping you tackle the moment at hand. Stress can also be chronic, when tension over difficult situations builds up in a seemingly endless stream of worry and fear. And according to a recent report from the American Psychological Association, American adults report feeling stressed over everything from personal concerns like money and relationships to societal concerns like mass shootings, crime, and climate change.
In addition, stress is not a simple feeling, with symptoms ranging from headaches and chest tightness to an upset stomach. "It is a very complex body-brain response," says Aysenil Belger, a biological psychologist at the University of North Carolina School of Medicine.
No matter what the cause, if someone constantly feels stressed, their health can suffer. Chronic stress has been associated with an increased risk of mental health concerns like depression and anxiety, and even physical health issues like heart disease. As a result, understanding the body's stress response—and finding ways to help individuals manage that stress—is crucial.
Belger and Alper Bozkurt, an electrical engineer at NC State University, are developing a device that could provide new insights into stress. Through a pilot award via the North Carolina Translational and Clinical Sciences (NC TraCS) Institute, the two researchers are building a stress-tracking tool, designed to be worn on a person's wrist.
The device will measure multiple biological markers associated with stress, providing new sources of data on how stress manifests in the body. This will allow researchers and clinicians to track stress over time in real time, and, potentially, help people get a better handle on their own stress.
Alper Bozkurt, PhD, MSc
Belger and Bozkurt first met through the Nanosystems Engineering Research Center for Advanced Self-Powered Systems of Integrated Sensors and Technologies (ASSIST). ASSIST is a National Science Foundation-funded, multi-university research center headquartered at NC State that Bozkurt co-directs, and which focuses on the development of wearable technology. The two scientists' research interests have natural overlaps. Bozkurt has spent much of his career studying wearable engineering of all kinds, including sensors to track health data for conditions such as asthma, diabetes, and mental health. Belger has spent her career studying the biology of various psychological conditions, a field ripe for study through wearable technology.
The two scientists have also gotten to know each other through a shared personal history. Both researchers are originally from Turkey and have become part of a network of Turkish-American scientists living and working in the Research Triangle area. This network includes Professor Aziz Sancar from UNC-Chapel Hill, a Nobel laureate in chemistry, who founded the Sancar Turkish Cultural & Community Center on Franklin Street.
Scientists collaborate and network together to make their science better...
"Scientists collaborate and network together to make their science better," Bozkurt says. "And when you come from a particular cultural background that also resonates well, you align in multiple directions."
That personal history is also part of what prompted Belger to first think about the idea of a wearable device to measure stress. In 1999, a magnitude 7.6 earthquake struck outside the Turkish city of İzmit, just a few dozen miles from Istanbul, in a region home to millions of people. Nearly 20,000 people died, with hundreds of thousands more injured, homeless, or displaced. And in the decades since, Turkey has also seen the influx of millions of refugees fleeing the Syrian Civil War.
When these humanitarian crises occurred, Belger says, she would have loved to have a device she could take into the field to understand the biology surrounding victims' mental health, especially among children who were impacted, and deliver timely, effective, targeted, and fast interventions to assist in their recovery.
"For these victims, if we're interested in understanding their experiences—especially how a one-year-old versus a five-year-old, a 10-year-old, and 18-year-old, are experiencing these events differently—we need to be able to collect data and information to develop better interventions targeted to their individual needs and circumstances," Belger says. "But we can't, because they're in very low resource environments necessitating adaptive low-cost and highly scalable and culturally adapted approaches."
Belger adds that we need to enhance our ability to measure and track well-being, especially in children who may not have full insight into their own feelings and thoughts. This will enable researchers to develop accurate, sustainable, and scalable digital health solutions that can accelerate the deployment of real-time, effective, and targeted interventions.
Even in areas of the world with a lot of resources, understanding the complex array of factors that contribute to individual stress experiences is complicated. Stress can't be captured through a single test or assessment, as the experience depends on multiple different physiological responses across the brain and body. "There are physiological and cognitive and brain and hormonal changes, including factors such as arousal," Belger says. When we feel stressed, our autonomic nervous system prompts the body to release the hormone adrenaline, which causes our blood pressure to increase and our heart rate to go up. The body's reaction also ricochets from the muscles, which tense up, to the lungs, which start to breathe more rapidly, and even to the digestive system, exacerbating stomachaches and nausea. In addition, the stress response includes the release of cortisol, along with other hormones, which targets a wide range of brain regions critical for decision making and emotion processing.
And these events don't take place in a vacuum. Our stress experiences are the product of our environment and the context in which these experiences occur—meaning any of these biological responses can only be understood in context to determine if they're adaptive or maladaptive.

Belger and Bozkurt's device will incorporate a slew of sensors outfitted to measure different aspects of the body's stress response. These sensors will pick up on heart rate, as well as heart rate variability, or the variation in the heart's rhythm, which can help elucidate how tense or relaxed a person is. In addition, the device will measure a person's electrodermal activity, or the change in the electrical properties of their skin, which can be used to measure part of the body's autonomic nervous system response. Finally, the device will measure the ambient temperature, relative humidity, and acoustic noise level of the person's surrounding environment.
Many mass-market wearable devices like fitness trackers and smartwatches can already measure things like heart rate and physical activity. But these devices aren't necessarily outfitted to be useful for researchers, Bozkurt says, as they don't provide the kind of high-resolution raw data that scientists need. In addition, these sorts of multi-purpose wearable devices are expensive and consume power very quickly, he adds.
If a device like the one Belger and Bozkurt are now testing were approved for use, it could prove to be vital to both patients and their doctors. Theoretically, the team says, a person wearing the device could be notified when their body begins to show signs of stress, prompting them, for instance, with calming exercises like deep breathing. In addition, data on their stress could be analyzed by a mental health professional, helping both doctor and patient spot patterns and trends in how a person's stress interacts with their life and better identify an individual's "triggers."

The team has focused their project specifically on adolescents and young adults, noting that most mental health conditions begin by age 24, and that nearly one-quarter of teenagers experience a "severe mental disorder." Belger also points out that these devices could help monitor stress in people who have trouble communicating, either due to disability or age—newborn babies, for example, aren't able to tell anyone when or why they're feeling the symptoms of stress.
The current prototype device has been engineered to only need charging every four weeks or so, helping people track stress over a long period of time with few interruptions. But the aim is to have the device charge only once a year—and eventually to avoid external charging completely by engineering the device to harvest energy from the thermal radiation and motion of the body. This feature, the main vision of the ASSIST Center that Bozkurt codirects, would make the device especially useful in areas with few resources and intermittent electricity, including areas that have recently undergone a humanitarian or natural disaster.
There's still plenty of testing needed before such a device could be used for clinical research, let alone given to patients for personal stress-tracking. But both Belger and Bozkurt say that collaborating with fellow Turkish-American scientists provides much more than just scientific insight—it's also a way to connect over food, music, language, and other elements of culture that remind them of their families and memories back in Turkey.
"Right now, I have more than 50 people I'm collaborating with," Bozkurt says. "My Turkish-American colleagues are a small subset of this, but with them I also have a beyond-science cultural connection, which is really nice to cherish and celebrate within the historical multicultural mosaic of the United States."
Belger echoes that sentiment: "I get very excited in this particular community, where I find all these individuals who share the science, but also share the culture, and how we communicate." She says that for her, this feeling of belonging and purpose was particularly ignited when she served as the President-elect of the Turkish-American Scientists and Scholars Association (TASSA).
"We talked about stress. Well, the other side of stress," she adds, "is that healing sense of belonging."
NC TraCS is the integrated hub of the NIH Clinical and Translational Science Awards (CTSA) Program at the University of North Carolina at Chapel Hill that combines the research strengths, resources, and opportunities of the UNC-Chapel Hill campus with partner institutions North Carolina State University in Raleigh and North Carolina Agricultural and Technical State University in Greensboro.